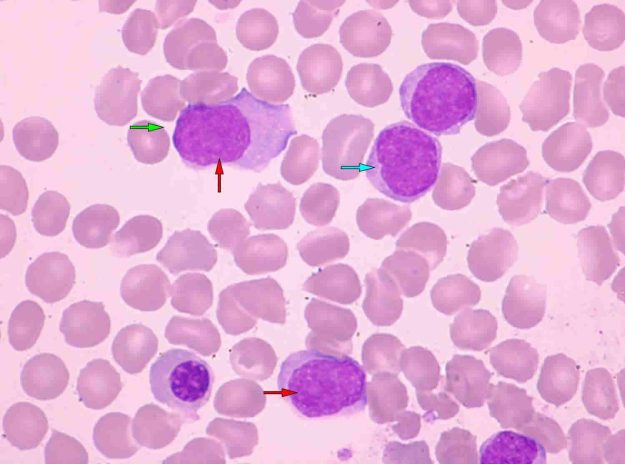

پنل فلوسایتومتری برای تشخیص CLL/SLL/PLL
Panel for diagnosis Chronic lymphocytic leukemia/small lymphocytic lymphoma (CLL/SLL/PLL)CD45, CD5, CD19, CD10, CD20, CD23, CD200, FMC7, Lambda, Kappa لوسمی لنفوسیتیک مزمن (CLL) و لنفومای لنفوسیتیک کوچک (SLL) دو بیماری خونی هستند که بطور عمده سلولهای B را درگیر میکنند و اغلب با افزایش تعداد سلولهای لنفوسیتی در خون و مغز استخوان مشخص میشوند. این بیماریها…
اطلاعات بیشتر